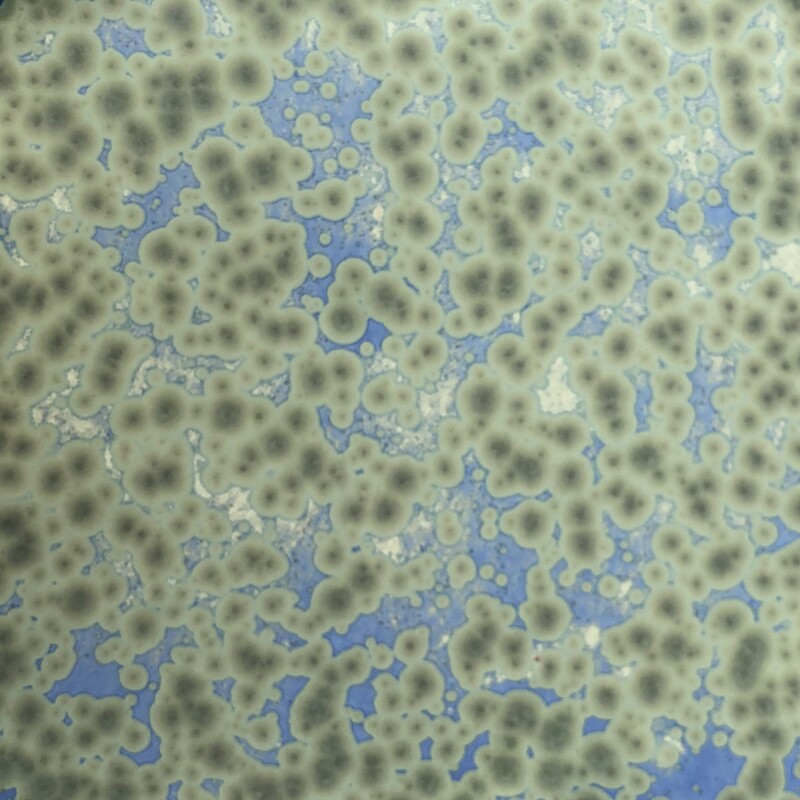

Mes émaux pour grès et porcelaine
Quelques exemples des émaux mis au point à l’atelier à voir plus en détail sur le Blog de Sabine
Le Bleu Okinawa
Un émail avec des nucléations foncées sur un fond turquoise et mat.

Le vert Lichen
Un émail qui passe du bleu clair au noir en passant par le vert avec des nucléations noires ou blanches.

Framboises et Myrtilles
Un émail qui montre des nucléations roses et bleues sur fond marron.

Komacu
Un émail turquoise transparent avec de petit cristaux blancs

Jun ou celadon
Des émaux très voisins turquoises ou verts brillants et transparents avec des micro-bulles qui leurs donnent de la profondeur.

Komori
Un émail avec des nucléations noires et blanches sur un fond bleu à vert

Murasakino
Un émail avec des nucléations violettes et roses sur un fond bleu foncé

Kaki
Un émail de la tradition chinoise, c’est un rouge de fer avec de la cendre d’os un vrai rouge avec des métallisations noires. Un super émail qui couvre bien ne coule pas et se tend parfaitement.

Yuki d’or vert
Un nouvel émail à la cendre chêne, nous l’avons appelé Yuki (la neige en japonais) car il montre des flocons blancs sur un fond coloré en vert.

Yuki d’or bleu
Un nouvel émail à la cendre chêne, nous l’avons appelé Yuki (la neige en japonais) car il montre des flocons blancs sur un fond coloré en vert ou bleu. Une variante transforme les flocons en paillettes d’or marron-dorées.

Tom Turner rouge de cuivre
Un bel émail rouge sang, coloré par le cuivre en oxydation, avec des fantômes bleu pâle, d’après une recette de

Serene Satin
Un émail étonnant car coloré par un peu de chrome qui au lieu d’être vert est coloré par des nucléations roses sur fond bleu turquoise. Vous trouverez sa formule et son histoire sur Glazy recette #242320

Nymphéas
Un émail doux et mat avec des nucléations vertes sur un fond bleu rappelant les nymphéas de Monet
Fluorescence
Des émaux nouveaux, blancs le jour, ils éclairent la nuit avec des couleurs intenses et irréelles. (Rouges, oranges, verts et même bleus). Ces émaux sont difficiles à photographier il faut les voir en vrai. Pour ces émaux on sort des matières premières classiques du céramiste et on introduit les terres rares.

